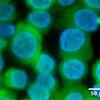
cells

A copy of a research abstract is available to working journalists only and may be obtained by contacting Preston M. Moretz in Temple University’s Communications Office, 215-204-4380 or [click-for-email].
Angiocidin, a novel tumor-inhibiting protein, has been shown to reduce acute myeloid leukemia (AML) cells in mice by almost two-thirds in pre-clinical experiments.
George P. Tuszynski, a professor of neuroscience in Temple University’s School of Medicine who discovered Angiocidin, presented the findings during the American Society of Hematology’s national meeting in Atlanta on Dec. 9.
AML causes certain white blood cells to stop maturing, resulting in their uncontrolled proliferation, which can lead to suppression of the immune system and often fatal secondary problems such as infections, including pneumonia, and an increased risk for bleeding.
Earlier studies using four AML cell lines and patient AML cells grown in petri dishes, Angiocidin demonstrated the ability to stimulate maturation in the affected white cells, causing them to behave and function like normal cells.
With 50 percent success in the in vitro patient studies, the researchers next focused on how Angiocidin would perform against cells from AML patients in vivo. Samples from a patient were injected into a special mouse model developed by Martin Carroll, associate professor of medicine at the University of Pennsylvania. Over a 14-week period, the leukemia cells engrafted to the bone marrow of the mice.
The mice were then given doses of Ara-C, Angiocidin or a combination of both. The chemotherapy agent Ara-C, or cytosine arabinoside, is standard-of-care for AML and kills cancer cells by inhibiting DNA synthesis.
Mice treated only with Angiocidin saw a 63 percent reduction in AML cells, while those treated with both experienced a 79 percent reduction in AML cells. Mice treated with Ara-C alone saw a reduction of only around 40 percent.
“One question we had is whether Angiocidin would be able to get into the bone marrow,” said Tuszynski. “These results clearly show that Angiocidin is able to prevent the growth of AML cells in the bone marrow.” However, Tuszynski cautioned that pre-clinical data is not always predictive of activity in humans.
While Ara-C and other drugs used to treat AML are highly toxic, Angiocidin has exhibited no evidence of toxicity, making it a potentially safer alternative treatment to standard-of-care, especially for elderly patients who can’t tolerate chemotherapy.
Tuszynski said that additional pre-clinical tests are being performed to gather more data and to determine an optimal dose of Angiocidin for patients. “Once we have all of our pre-clinical data together, we will be able to begin preparing for a clinical trial in humans,” he said.
The pre-clinical testing of Angiocidin has been funded through a grant from Philadelphia’s University City Science Center.
A start-up company, Diffregen LLC, has licensed Angiocidin from Temple. They recently submitted a small business innovation research (SBIR) grant proposal to the National Institutes of Health to support product development activities for this novel treatment for AML and potentially other cancers.
